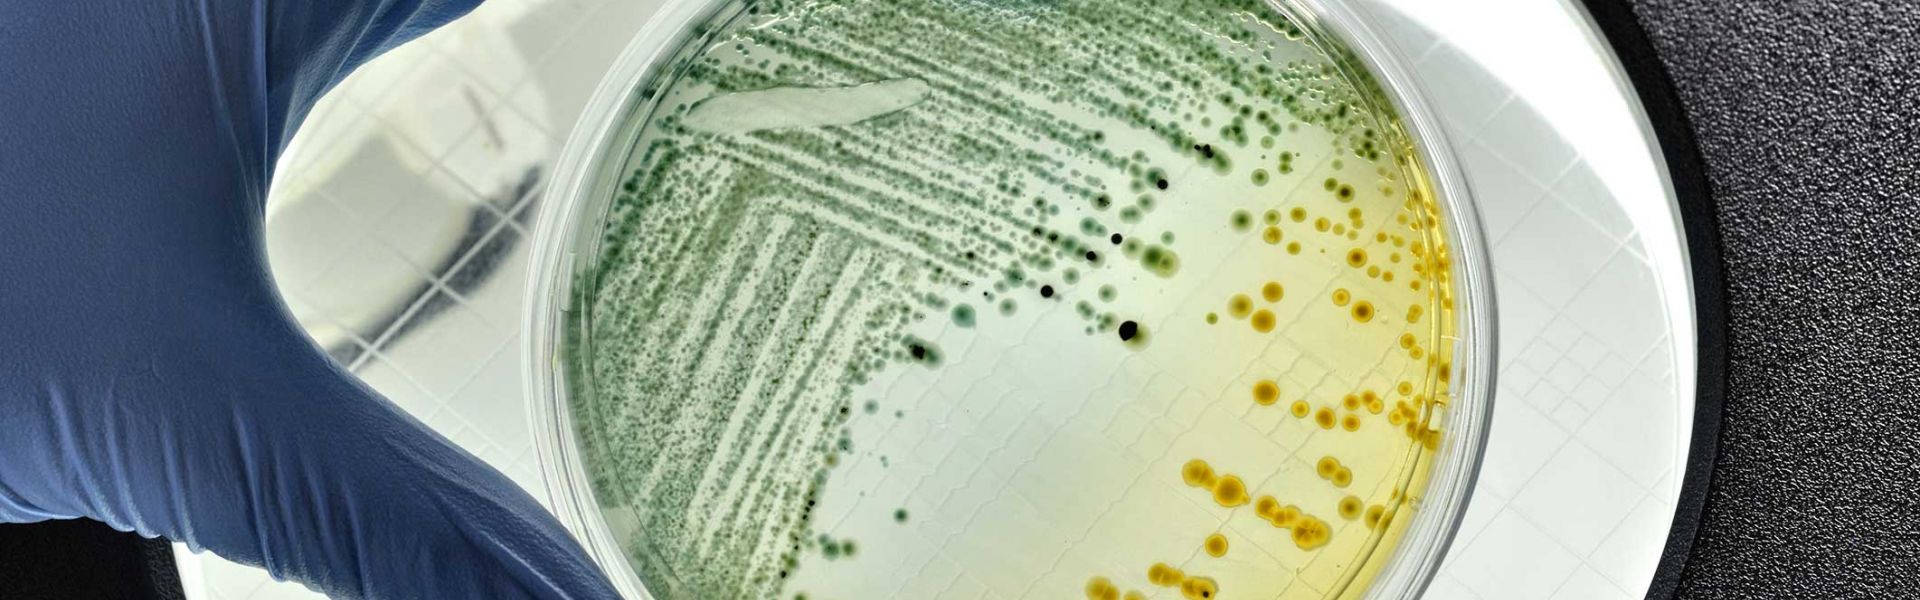

Aliments contaminés par la bactérie E. coli : quels effets sur la santé et comment prévenir les infections ?
Cet article est republié à partir de The Conversation sous licence Creative Commons. Lire l’article original.
La bactérie Escherichia coli (E. coli) a récemment fait l’actualité en France, dans le cadre de l’importante vague d’intoxications alimentaires qu’elle a provoquée. Une épidémie due à des pizzas contaminées qui a touché 56 personnes, dont 55 enfants, et a provoqué deux décès.
Cette bactérie est pourtant naturellement présente dans notre microflore digestive. Si la plupart des souches d’E. coli sont sans danger pour l’Homme, d’autres peuvent être à l’origine d’infections ou porter des gènes de résistance aux antibiotiques. Parmi les souches pathogènes, les E. coli entérohémorragiques ou EHEC sont responsables d’infections d’origine alimentaire parfois sévères, principalement chez les jeunes enfants et les personnes âgées.
En France, les aliments les plus souvent incriminés dans les épidémies sont la viande hachée de bœuf (consommée crue ou insuffisamment cuite) et certains fromages au lait cru.
Pour mieux caractériser ce danger, l’Agence nationale de sécurité sanitaire de l’alimentation, de l’environnement et du travail (Anses) définit les souches d’EHEC les plus souvent associées à des formes graves et développe de méthodes de biologie moléculaire pour les détecter rapidement dans les aliments. L’Agence réalise également des évaluations de risques sur l’ensemble de la chaîne alimentaire, et émet des recommandations aux professionnels, aux pouvoirs publics et aux consommateurs pour diminuer le risque de maladie.
Le danger des E. coli entérohémorragiques
E. coli est une entérobactérie, c’est-à-dire une bactérie qui réside dans le tube digestif de l’être humain et des animaux à sang chaud. Il en existe de nombreux types, ou souches, qui sont pour la plupart inoffensifs. Certaines, toutefois, sont pathogènes. Il s’agit de souches ayant acquis des gènes de virulence leur conférant des propriétés particulières.
Parmi les souches pathogènes, les E. coli entérohémorragiques sont responsables de troubles variés, allant d’une diarrhée bénigne à des formes plus graves comme des diarrhées hémorragiques pouvant évoluer vers des atteintes rénales sévères telles que le syndrome hémolytique et urémique (SHU).
Ces souches bactériennes colonisent le tube digestif du malade et libèrent dans l’intestin une toxine (Shigatoxine, aussi appelée vérotoxine). Celle-ci est ensuite véhiculée vers ses organes cibles par le sang, où elle sera responsable de lésions vasculaires aux niveaux intestinal, rénal et cérébral.
Les E. coli entérohémorragiques (EHEC) sont aussi dénommées STEC ou VTEC (pour Shigatoxin/Verotoxin producing E. coli) en raison de la production d’une toxine nommée Shigatoxine/Verotoxine. CDC/National Escherichia, Shigella, Vibrio Reference Unit at CDC/Janice Haney Carr
L’exposition à un très faible nombre de cellules de cette bactérie peut suffire à déclencher l’infection. Pour les enfants de moins de 5 ans, l’ingestion de 500 bactéries est associée à une très forte probabilité de déclencher la maladie. Par comparaison, des doses 10 à 100 fois plus élevées sont nécessaires pour d’autres bactéries pathogènes comme les salmonelles.
Les premiers symptômes surviennent en moyenne 3 à 4 jours après ingestion de la bactérie et sont gastro-intestinaux : crampes abdominales et diarrhée initialement aqueuse puis sanglante. Les patients présentent peu ou pas de fièvre.
La maladie évolue vers un syndrome hémolytique et urémique (SHU) dans 5 à 8 % des cas. Les symptômes du SHU surviennent en général dans les sept jours qui suivent le début de la diarrhée. Les signes évocateurs sont une grande fatigue, une pâleur et une diminution du volume des urines. Le SHU nécessite une prise en charge hospitalière avec, pour les formes les plus graves, dialyse et/ou transfusion sanguine.
Des complications neurologiques graves peuvent apparaître dans 25 % des cas de SHU et une insuffisance rénale chronique est observée chez 50 % des survivants. La létalité du SHU chez l’enfant varie de 3 à 5 % dans la littérature scientifique, et elle est de 1 % selon les données françaises de surveillance.
Caractéristiques des infections aux EHEC : chronologie d’apparition des symptômes et leurs possibles degrés de gravité (diarrhées simples à sanglantes, avec risques de séquelles, décès…). Anses, Fourni par l'auteur
Les populations les plus à risque de développer des symptômes ou des formes graves de la maladie (diarrhées sanglantes, SHU) sont les enfants de moins de 15 ans (surtout en dessous de 5 ans) et les personnes âgées. Chaque année, environ 140 cas de SHU infantiles sont notifiés à Santé publique France.
Où et quand se produisent les contaminations ?
Les ruminants, en particulier les bovins, sont des porteurs sains de ces bactéries. Les bactéries présentes dans leurs matières fécales peuvent ainsi contaminer les produits animaux (viandes et produits laitiers) et l’environnement (sol, eau).
La principale voie de transmission des EHEC est la consommation d’aliments ou d’eau contaminés. La contamination se produit par exemple à l’abattoir pour les viandes (via la dépouille ou après éviscération des animaux), ou au moment de la traite pour le lait, en particulier lorsque les mesures d’hygiène ne sont pas appliquées.
En ce qui concerne les végétaux, cette contamination peut intervenir lors de l’épandage de fumiers ou d’effluents d’élevages sur les sols où ils sont cultivés, ou lors de l’utilisation d’eau d’irrigation contaminée.
L’eau de boisson peut être contaminée accidentellement ou lors d’un défaut de potabilisation. Enfin, les aliments peuvent être contaminés au moment de leur préparation du fait d’une mauvaise hygiène des mains.
D’autres voies de contamination sont possibles par contact avec des animaux porteurs (par exemple lors de visite de fermes) ou lors d’activités de baignades dans des eaux souillées. La transmission inter-humaine est également possible (par voie féco-orale) et survient principalement en milieu familial ou dans des collectivités de jeunes enfants (crèches).
Cycle de transmission et de contamination des aliments depuis les ruminants porteurs de la bactérie pathogène. EcL lab -- Université de Montréal, Author provided
Les aliments impliqués dans les épidémies
Les principaux aliments mis en cause lors d’épidémies d’infections à EHEC sont la viande hachée de bœuf insuffisamment cuite, les produits laitiers non pasteurisés (lait cru et fromages au lait cru), les végétaux crus (salade, jeunes pousses, graines germées), les jus de fruits ou de légumes non pasteurisés ou encore l’eau de boisson souillée.
En France, dix épidémies d’infections à EHEC ont été détectées et investiguées entre 2005 et 2020. Six d’entre elles étaient liées à des fromages au lait cru. Les fromages incriminés étaient des fromages à pâtes molles à croûte fleurie (comme le camembert, le brie) et les fromages à pâtes pressées non cuites à affinage court (comme le reblochon, le saint-nectaire). Trois étaient liées à des viandes hachées de bœuf et une à des graines germées.
Les farines pouvant également être contaminées, la consommation de pâte crue ou insuffisamment cuite (pâte à gâteaux, pâte à pizza) a récemment été à l’origine d’épidémies aux États-Unis, au Canada et plus récemment en France. En 2022, des pizzas surgelées contaminées ont été identifiées à l’origine de 56 cas (55 enfants et un adulte) survenus entre janvier et avril 2022.
Comment prévenir les infections
Tout au long de la chaîne alimentaire (élevage, transformation, distribution), les professionnels de l’agroalimentaire doivent appliquer de bonnes pratiques d’hygiène et des mesures spécifiques pour maîtriser les contaminations. Des autocontrôles doivent par ailleurs être réalisés afin de surveiller et de vérifier l’efficacité des mesures mises en place.
En cas de détection de bactéries dans les aliments et/ou d’apparition de cas humains, les mesures de retrait et/ou de rappel des produits mis sur le marché peuvent être déclenchées en lien avec les pouvoirs publics. La liste des produits soumis à un processus de rappel est consultable sur le site rappel.conso.gouv.fr.
Au niveau du consommateur, la prévention des infections à EHEC par voie alimentaire est essentiellement basée sur le respect des règles d’hygiène et l’éviction de certains aliments ou pratiques de consommation, en particulier pour les populations les plus sensibles.
Ainsi, les consommateurs peuvent éviter les infections en appliquant les mesures suivantes :
-
Se laver les mains avec du savon en sortant des toilettes, avant la préparation et la prise des repas, et après avoir manipulé des denrées alimentaires crues ou non ;
-
Laver soigneusement et éplucher si possible les légumes, mais aussi les fruits et les herbes aromatiques, en particulier ceux qui sont consommés crus ;
-
Pour les populations sensibles (jeunes enfants et personnes âgées) : cuire à cœur (70 °C) les viandes hachées et les produits à base de viande hachée, éviter la consommation de lait cru et de produits au lait cru (à l’exception des fromages à pâte pressée cuite) et celle de produits crus ou insuffisamment cuits à base de farine.
Pour conclure, les complications des infections aux EHEC sont rares mais sévères et touchent principalement les jeunes enfants et les personnes âgées en France. Comme pour l’ensemble des infections d’origine alimentaire, la stratégie de réduction du risque est fondée essentiellement par la prévention des contaminations tout au long de la chaîne alimentaire avant la remise au consommateur.
Les agences sanitaires comme l’Anses conduisent des travaux visant à identifier les mesures les plus efficaces pour réduire le risque de maladie. Les consommateurs ont toutefois un rôle essentiel en appliquant des mesures d’hygiène simples et en évitant, pour les populations sensibles, la consommation de certains aliments.


